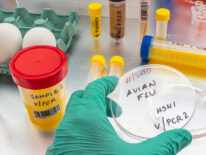
Detectan en España el primer caso de gripe aviar en humanos, el segundo en Europa

Primer “potencial feminicida” que usará tobillera electrónica, ya está registrado

A tres años del primer caso de Covid, Mazzoleni dice que las medidas fueron efectivas

Chile confirma su primer caso de gripe aviar en un lobo marino

Detectan el primer caso de la ‘ameba comecerebros’ en Corea del Sur

Detectan el primer caso de lesión grave en el país por uso de vapeador
Detectan en España el primer caso de gripe aviar en humanos, el segundo en Europa

Perú confirma primer niño con viruela del mono

Confirman la primera coinfección por VIH, viruela del mono y covid-19


